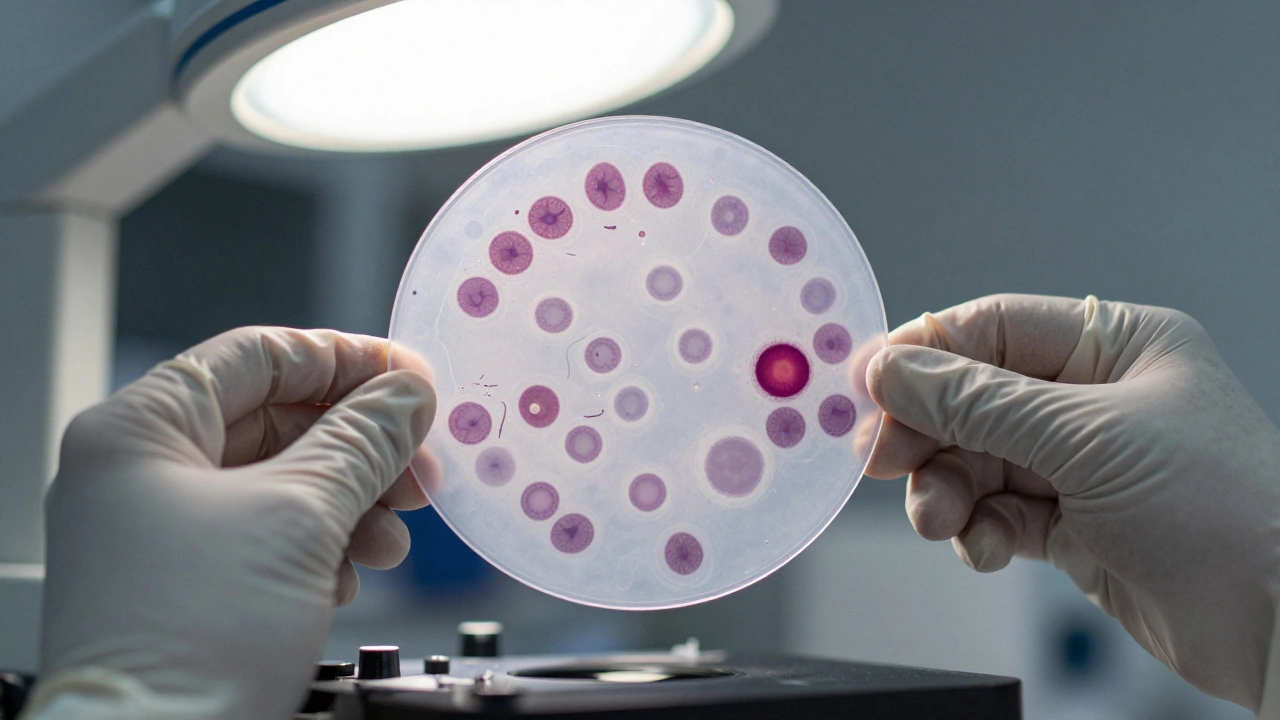
Микроскопический вид мазка крови с аномальными формами клеток

Если вам сказали, что у вас «проблемы с кровью», первое, что приходит в голову - это сдать анализ. Но какой именно? Не все анализы крови одинаковы. Некоторые показывают, есть ли инфекция, другие - как работает печень, а третьи - именно то, что происходит с самой кровью: её клетками, кислородом, свёртыванием. Если вы чувствуете слабость, часто устаёте, замечаете синяки без причин, у вас частые носовые кровотечения или кожа стала бледной - это не просто «всё плохо». Это сигнал, что нужно смотреть на кровь подробно.
Общий анализ крови - первый шаг
Это самый простой и самый важный тест, который назначают при любых подозрениях на проблемы с кровью. Его ещё называют «клинический анализ» или «общий анализ крови (ОАК)». Он показывает три главные группы клеток: эритроциты, лейкоциты и тромбоциты. Если что-то с ними не так - это сразу видно.
Эритроциты переносят кислород. Их количество и уровень гемоглобина показывают, достаточно ли кислорода доходит до тканей. Низкий гемоглобин - это анемия. Она может быть из-за нехватки железа, витамина B12, хронической потери крови (например, при менструациях или язве) или болезни костного мозга. Если гемоглобин 80 г/л вместо нормы 120-140, это уже серьёзно. Не просто «усталость» - это организм в режиме выживания.
Лейкоциты - это защитники. Их число говорит о том, есть ли инфекция, воспаление или даже лейкемия. Если лейкоцитов слишком много - организм борется. Если слишком мало - он не может защищаться. Важно не только общее число, но и формула: какие именно типы лейкоцитов преобладают. Например, рост нейтрофилов - признак бактериальной инфекции, а эозинофилов - аллергии или паразитов.
Тромбоциты отвечают за свёртывание. Если их мало - появляются синяки, кровотечения из носа, дёсен. Если много - повышается риск тромбов. Норма - от 180 до 320 тысяч на микролитр. Ниже 50 тысяч - уже риск спонтанных кровотечений. Это не просто цифра. Это вопрос жизни.
Биохимический анализ крови - что ещё скрывает кровь
Общий анализ показывает клетки, а биохимия - жидкую часть крови: плазму. Здесь смотрят на железо, ферритин, витамин B12, фолиевую кислоту, билирубин, белки, электролиты. Эти показатели объясняют, почему клетки крови не работают.
Например, если у вас низкий гемоглобин, но железо в норме - значит, проблема не в питании. Возможно, это хроническое воспаление, при котором железо «прячется» в печени и не попадает в эритроциты. Тогда нужно смотреть на ферритин - он показывает запасы железа в организме. Низкий ферритин - значит, железа действительно мало. Высокий ферритин при низком гемоглобине - это сигнал на воспаление или болезнь печени.
Витамин B12 и фолиевая кислота нужны для производства эритроцитов. Их нехватка вызывает мегалобластную анемию. Это не просто «усталость». Клетки крови становятся огромными, неправильной формы, и не могут нормально работать. Часто это связано с нарушением всасывания в кишечнике - например, при аутоиммунном гастрите или после операций на желудке.
Билирубин - продукт распада эритроцитов. Если он высокий, значит, клетки крови разрушаются слишком быстро. Это может быть признаком гемолитической анемии - когда иммунная система ошибочно атакует свои же эритроциты. Такое бывает после инфекций, при аутоиммунных болезнях или при наследственных нарушениях, как сфероцитоз.
Анализ на ретикулоциты - как костный мозг реагирует
Если у вас анемия, врач должен понять: костный мозг пытается компенсировать потерю клеток или он «выключен»? Для этого сдают анализ на ретикулоциты - это молодые эритроциты, только что вышедшие из костного мозга.
Если ретикулоцитов много - костный мозг работает. Проблема, скорее всего, в потере крови или в разрушении эритроцитов. Если ретикулоцитов мало - костный мозг не производит новые клетки. Это уже серьёзно: может быть апластическая анемия, лейкемия, последствия химиотерапии или тяжёлый дефицит питательных веществ.
Этот анализ не делают в каждой лаборатории. Но если общий анализ показал анемию, а причина неясна - его обязательно нужно сдать. Без него вы не узнаете, почему кровь не восстанавливается.

Свертывающая система - когда кровь не сворачивается или сворачивается слишком сильно
Проблемы с кровью - это не только мало клеток. Иногда клеток много, но они не работают. Например, тромбоциты не склеиваются, или белки свёртывания не активируются. Тогда даже маленькая царапина может вызвать кровотечение. А иногда, наоборот, кровь слишком густая - и образуются тромбы.
Для этого сдают коагулограмму. Она включает: протромбиновое время (ПВ), МНО, активированное частичное тромбопластиновое время (АЧТВ), фибриноген, D-димер. Эти показатели говорят, как быстро кровь сворачивается.
Если МНО выше 1.5 - это значит, что кровь плохо сворачивается. У людей на варфарине это нормально, но если вы не принимаете антикоагулянты - это тревожный знак. Может быть болезнь печени, дефицит витамина K или наследственное нарушение.
D-димер - маркер тромбов. Если он повышен, значит, в организме где-то идёт образование и разрушение сгустков. Это может быть венозный тромбоз, тромбоэмболия лёгочной артерии, или даже сепсис. Но D-димер не говорит, где именно тромб - только что он есть.
Что делать, если результаты не в норме
Не паникуйте, если один показатель не в норме. Анализы - это не приговор. Они - подсказки. Например, низкий гемоглобин у женщины в возрасте 30 лет - чаще всего из-за менструаций и нехватки железа. Низкий гемоглобин у мужчины 55 лет - уже требует проверки на скрытую кровопотерю из ЖКТ, вплоть до колоректального рака.
Если у вас анемия, но железо в норме - сдайте ферритин, витамин B12, фолиевую кислоту, ретикулоциты. Если тромбоцитов мало - проверьте печень, щитовидную железу, аутоиммунные маркеры. Если лейкоциты необычно высокие - сдайте мазок крови под микроскопом. Это не сложная процедура, но она даёт ответы, которые общий анализ не даёт.
Нет смысла сдавать десяток анализов сразу. Начните с общего анализа крови. Если есть отклонения - врач скажет, какие следующие тесты нужны. Самостоятельно заказывать биохимию или коагулограмму без показаний - пустая трата денег и нервов.
Когда срочно идти к врачу
Не ждите, пока «само пройдёт», если:
- Гемоглобин ниже 80 г/л
- Тромбоцитов меньше 50 000/мкл
- Лейкоцитов меньше 2 000/мкл или выше 30 000/мкл
- Появились синяки без причины, кровотечения из носа, дёсен, мочи, кала
- Кожа и слизистые стали желтоватыми
- Ощущение сильной слабости, одышка при ходьбе, учащённое сердцебиение
Это не «усталость от работы». Это признаки, что кровь не справляется со своей основной задачей - кормить ткани кислородом, защищать от инфекций, останавливать кровотечения. Игнорировать это - опасно.
Что можно сделать дома, пока ждёте анализы
Пока вы ждёте записи к врачу или результатов, не пытайтесь «вылечиться» витаминами из аптеки. Но можно поддержать организм:
- Ешьте продукты с железом: печень, говядина, бобовые, шпинат, гранаты
- Пейте чай с лимоном - витамин С помогает усваивать железо
- Избегайте кофе и молока за час до и после еды - они мешают усвоению железа
- Не принимайте без назначения аспирин или НПВП - они могут вызвать кровотечения
- Следите за тем, чтобы не было потери крови - например, при менструациях используйте более эффективные средства
Это не замена лечению. Это просто помощь организму, пока вы не узнаете причину.
Что ещё проверяют при подозрении на болезни крови
Если общие анализы не дают ответа, но симптомы остаются - врач может назначить:
- Анализ на витамин B12 и фолиевую кислоту
- Анализ на ферритин и трансферрин
- Мазок крови под микроскопом - чтобы увидеть форму клеток
- Биопсию костного мозга - если подозревают лейкемию или апластическую анемию
- Генетические тесты - если есть семейный анамнез
Это уже не «просто анализы». Это диагностика серьёзных заболеваний. Но даже в этих случаях раннее выявление - это шанс на полное выздоровление.
Проблемы с кровью - не редкость. Но они лечатся. Главное - не игнорировать сигналы. Сдать общий анализ крови - это как проверить топливо в машине. Если топливо плохое - машина не поедет. Если кровь плохая - организм не работает. Не ждите, пока всё сломается. Проверьте - и действуйте.





